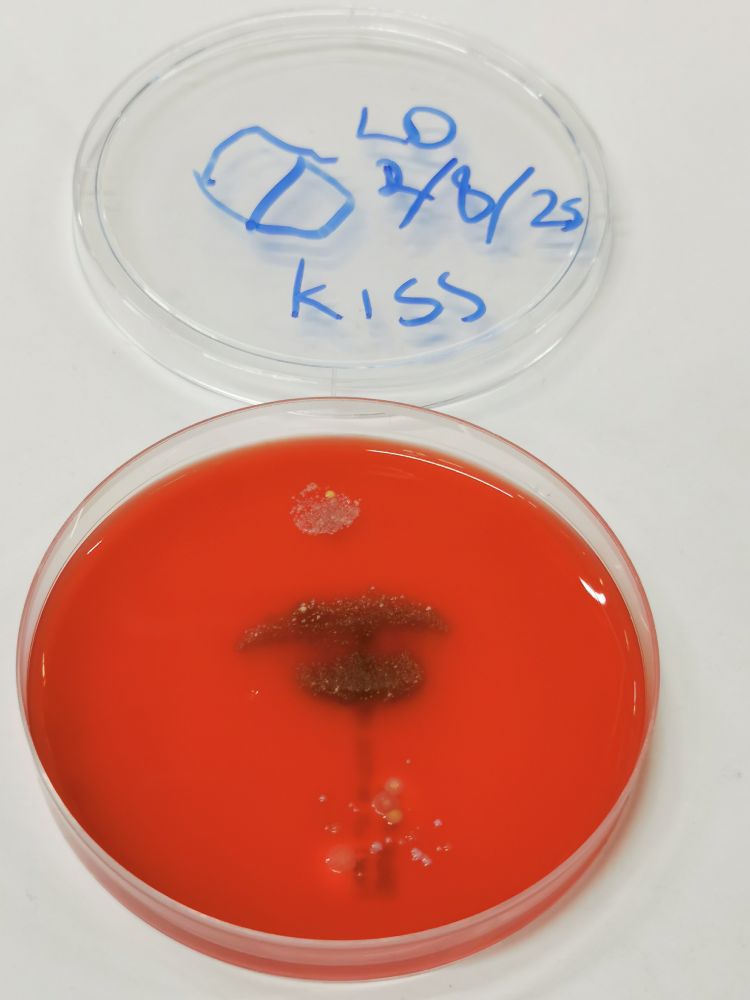
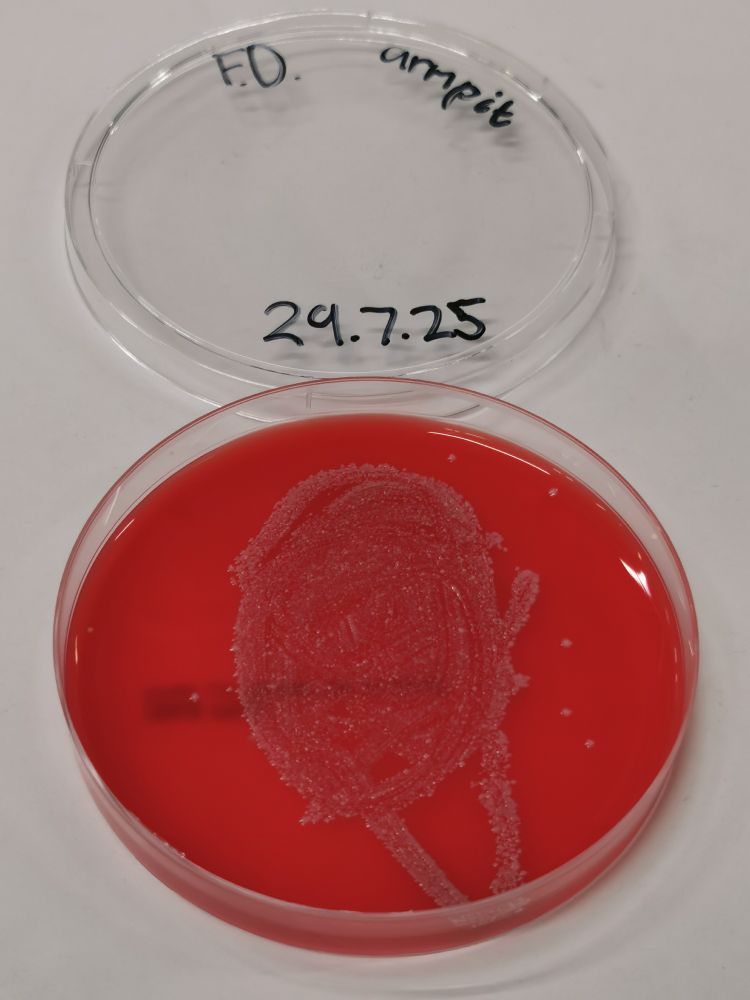

Superbugs 🦠🔬🏫🧒🏽
@superbugs.bsky.social
The microbial worlds in, on and around us • Health, disease, infection, hygiene, antibiotics, vaccines • Education, engagement, events, pop-up shops • Games, stories, info, activities, fun • English, Cymraeg, Gàidhlig, Gaeilge
www.superbugs.online
www.superbugs.online
Happy #Halloween!
Check out our collection of #spooky #agarart from across the internet.
👉🏼 www.superbugs.online/superblog/ha...
🎃👻💀🦴🧟🧛🏼🕷️👹
Check out our collection of #spooky #agarart from across the internet.
👉🏼 www.superbugs.online/superblog/ha...
🎃👻💀🦴🧟🧛🏼🕷️👹




October 31, 2025 at 1:14 PM
Happy #Halloween!
Check out our collection of #spooky #agarart from across the internet.
👉🏼 www.superbugs.online/superblog/ha...
🎃👻💀🦴🧟🧛🏼🕷️👹
Check out our collection of #spooky #agarart from across the internet.
👉🏼 www.superbugs.online/superblog/ha...
🎃👻💀🦴🧟🧛🏼🕷️👹
How it started How it's going


October 22, 2025 at 4:18 PM
How it started How it's going
On the road again! Off to Caerphilly tomorrow to have some fun and tell school children about infection, health and hygiene.

October 8, 2025 at 4:44 PM
On the road again! Off to Caerphilly tomorrow to have some fun and tell school children about infection, health and hygiene.
No worries, we will be back at some point.
After the event is before the event.
Meanwhile:
After the event is before the event.
Meanwhile:

August 8, 2025 at 7:20 PM
No worries, we will be back at some point.
After the event is before the event.
Meanwhile:
After the event is before the event.
Meanwhile:

August 6, 2025 at 3:18 PM
We have now uploaded the last remaining photos of the body swabs we have been taking over the past four weeks - 1,254 in total.
Check out the results here:
👉🏼 www.superbugs.online/pop-up-2025/...
Here's one last kiss for you... 👄🦠🧫🤢
Check out the results here:
👉🏼 www.superbugs.online/pop-up-2025/...
Here's one last kiss for you... 👄🦠🧫🤢

August 5, 2025 at 6:57 PM
We have now uploaded the last remaining photos of the body swabs we have been taking over the past four weeks - 1,254 in total.
Check out the results here:
👉🏼 www.superbugs.online/pop-up-2025/...
Here's one last kiss for you... 👄🦠🧫🤢
Check out the results here:
👉🏼 www.superbugs.online/pop-up-2025/...
Here's one last kiss for you... 👄🦠🧫🤢
More kisses from South Wales.
💋🦠🧫
💋🦠🧫

August 5, 2025 at 10:37 AM
More kisses from South Wales.
💋🦠🧫
💋🦠🧫
So many questions.

August 4, 2025 at 7:41 PM
So many questions.
We would have not been able to deliver such an ambitious pop-up shop over the past 4 weeks without an army of 54 enthusiastic and tireless volunteers from across Cardiff Uni, Cardiff Met and Swansea Uni, and beyond!
THANK YOU !!
THANK YOU !!

August 3, 2025 at 7:27 PM
We would have not been able to deliver such an ambitious pop-up shop over the past 4 weeks without an army of 54 enthusiastic and tireless volunteers from across Cardiff Uni, Cardiff Met and Swansea Uni, and beyond!
THANK YOU !!
THANK YOU !!
Kisses from South Wales!
💋🦠🧫
💋🦠🧫




August 3, 2025 at 7:23 PM
Kisses from South Wales!
💋🦠🧫
💋🦠🧫
Our very special visitor no. 4,955 - the last person in our 2025 pop-up shop!

August 3, 2025 at 7:02 PM
Our very special visitor no. 4,955 - the last person in our 2025 pop-up shop!
And that's a wrap. We have closed now, after 4 weeks of Superbugs fun for schools, families and everyone interested in the microbial world in, on and around us.
Thank you to everyone visiting us and supporting us!
Thank you to everyone visiting us and supporting us!




August 3, 2025 at 7:01 PM
And that's a wrap. We have closed now, after 4 weeks of Superbugs fun for schools, families and everyone interested in the microbial world in, on and around us.
Thank you to everyone visiting us and supporting us!
Thank you to everyone visiting us and supporting us!
Day 27: Our busiest day ever!




August 2, 2025 at 7:00 PM
Day 27: Our busiest day ever!
Day 26: Still going strong. Our last Friday, and what a great days it's been!




August 1, 2025 at 5:00 PM
Day 26: Still going strong. Our last Friday, and what a great days it's been!
And this is what we have been growing from a baby's foot, an inhaler, jewellery and an armpit.
👉🏼 www.superbugs.online/pop-up-2025/...
👉🏼 www.superbugs.online/pop-up-2025/...

August 1, 2025 at 7:25 AM
And this is what we have been growing from a baby's foot, an inhaler, jewellery and an armpit.
👉🏼 www.superbugs.online/pop-up-2025/...
👉🏼 www.superbugs.online/pop-up-2025/...
Day 25: More than 600 treasure hunts and more than 700 sticker challenges completed so far, and already more than 1,000 body swabs cultured on agar plates.
Can we reach 5,000 visitors before we close on Sunday?
👉🏼 www.superbugs.online/pop-up-2025
Can we reach 5,000 visitors before we close on Sunday?
👉🏼 www.superbugs.online/pop-up-2025




August 1, 2025 at 7:17 AM
Day 25: More than 600 treasure hunts and more than 700 sticker challenges completed so far, and already more than 1,000 body swabs cultured on agar plates.
Can we reach 5,000 visitors before we close on Sunday?
👉🏼 www.superbugs.online/pop-up-2025
Can we reach 5,000 visitors before we close on Sunday?
👉🏼 www.superbugs.online/pop-up-2025
Come and find us in the St David's Centre in Cardiff!
July 31, 2025 at 8:33 AM
Come and find us in the St David's Centre in Cardiff!
A reminder that our pop-up shop in the St David's Centre is only open until 3rd August!




July 30, 2025 at 5:35 PM
A reminder that our pop-up shop in the St David's Centre is only open until 3rd August!
One can never have enough blood agar plates these days.

July 30, 2025 at 9:21 AM
One can never have enough blood agar plates these days.
Day 23: Our busiest day so far!




July 29, 2025 at 5:09 PM
Day 23: Our busiest day so far!
Some stunning artwork produced in the arts & crafts corner of our pop-up shop!




July 29, 2025 at 5:04 PM
Some stunning artwork produced in the arts & crafts corner of our pop-up shop!
Thank you to the Greek School of Wales for visiting our pop-up shop!




July 23, 2025 at 8:11 PM
Thank you to the Greek School of Wales for visiting our pop-up shop!
Day 14: Our last school visit. Thanks to St Joseph's Primary for the great time today!
In total we have now hosted 11 classes from 8 different primary and secondary schools in our pop-up shop - almost 300 pupils all the way from year 2 to year 9, together with their teachers.
In total we have now hosted 11 classes from 8 different primary and secondary schools in our pop-up shop - almost 300 pupils all the way from year 2 to year 9, together with their teachers.




July 18, 2025 at 10:46 PM
Day 14: Our last school visit. Thanks to St Joseph's Primary for the great time today!
In total we have now hosted 11 classes from 8 different primary and secondary schools in our pop-up shop - almost 300 pupils all the way from year 2 to year 9, together with their teachers.
In total we have now hosted 11 classes from 8 different primary and secondary schools in our pop-up shop - almost 300 pupils all the way from year 2 to year 9, together with their teachers.
Day 11: Our youngest visitors so far, demonstrating that our pop-up shop experience works equally well for year 2 and year 9 pupils.




July 17, 2025 at 9:53 PM
Day 11: Our youngest visitors so far, demonstrating that our pop-up shop experience works equally well for year 2 and year 9 pupils.





